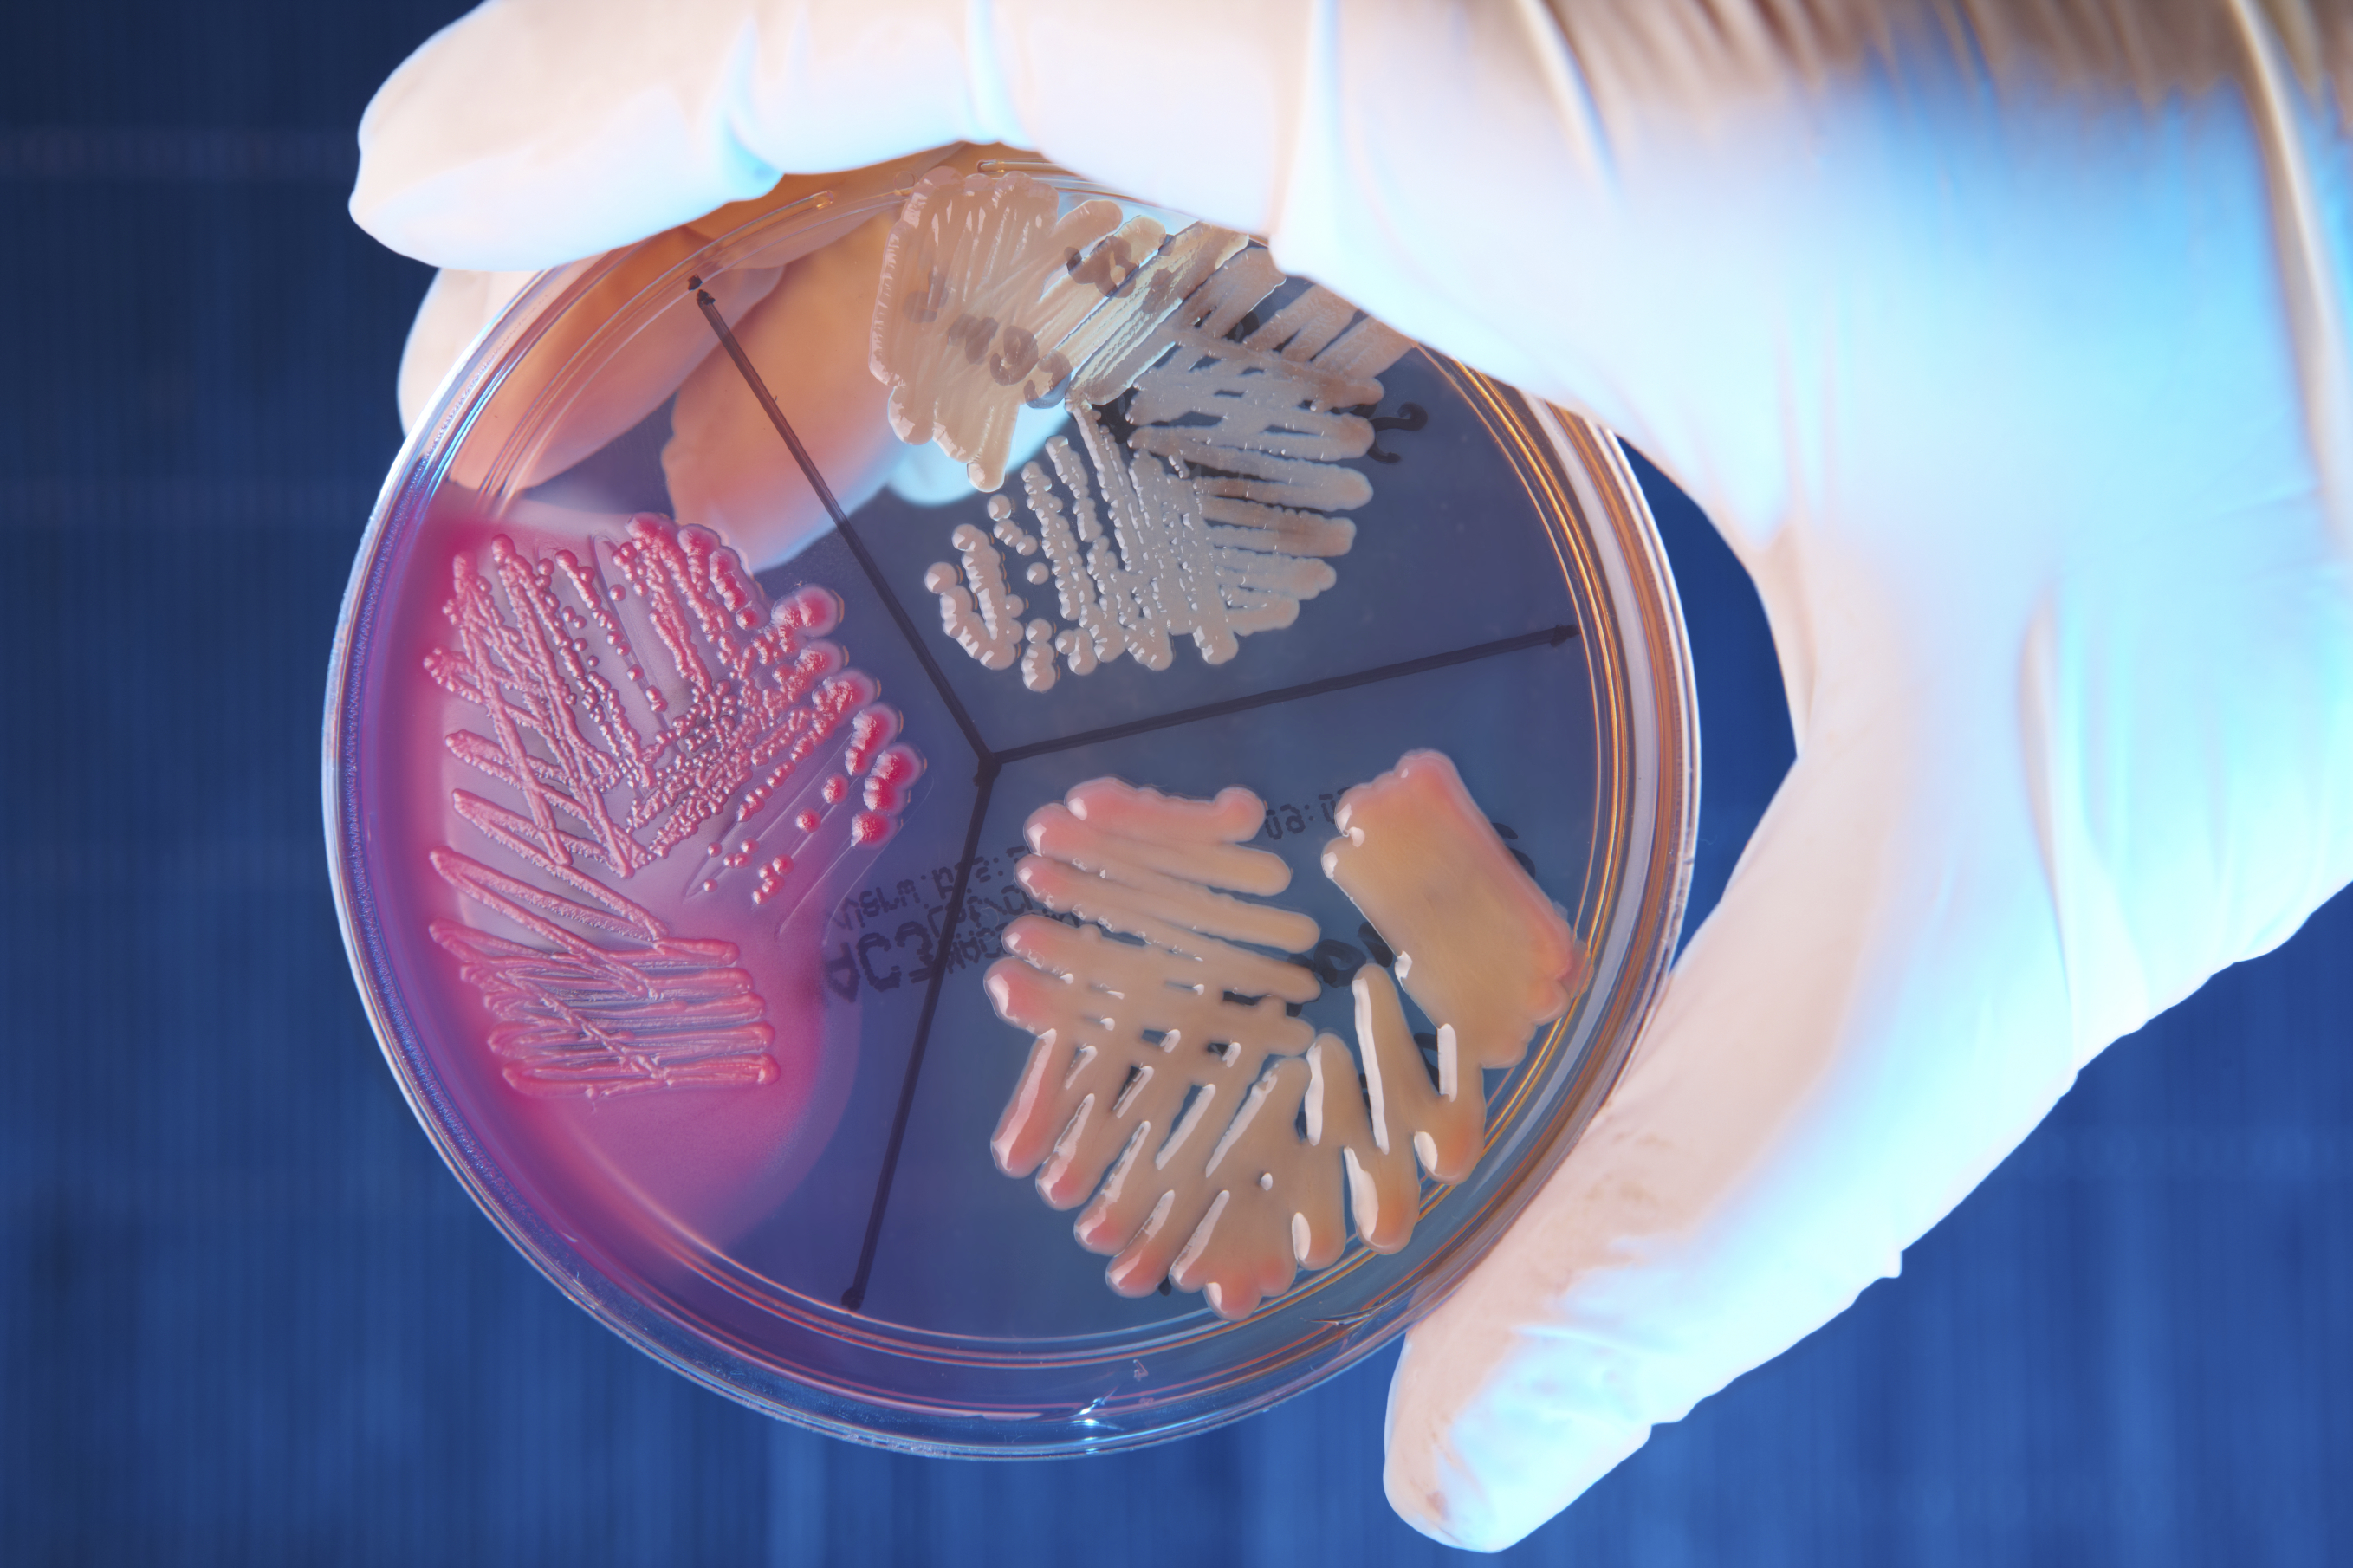
Istock 000012037671Large

This course considers the nature of micro-organisms, contamination sources and control, sterilisation and disinfection and testing methodology (including modern counting and identification techniques).
This training reviews the impact of microbiology on many aspects of pharmaceutical manufacture and is ideal for those seeking a clearer understanding of the topic. This includes trainee QPs who may find attendance beneficial before participating in our QP Pharmaceutical Microbiology module.
Interested in pharmaceutical microbiology training for your team? Contact us today.
This course will be of value to all personnel whose roles would benefit from a clearer understanding of this specialist area. This course is ideal for those new to the pharmaceutical industry working in production, technical support, quality control and quality assurance roles. In addition, it will also be of benefit to maintenance and support engineers who are involved in production areas and utilities.

This course includes the following topics:

The five types of microbes

Microbial ecology

Microbiological techniques

Infectious diseases – transmission and diagnosis

Infectious diseases – prevention, treatment and AMR

Assessment/quiz
By the end of the course you will be able to:

Compare and contrast the fundamental characteristics of the five major groups of microbes including structure, nutrition and replication, and how they are affected by environmental factors

Describe methods used to safely handle, culture, enumerate, identify and observe microbes including microscopy, batch and continuous culture, aseptic technique, PCR and RT-PCR, serological assays, biological hazard categories

Discuss how microbes interact with other organisms and in communities, resulting in outcomes ranging from disease to symbiosis

Explain how pathogens cause disease, how infectious diseases are transmitted, diagnosed, treated and prevented, including the main mechanisms of antimicrobial action and how microbes evolve antimicrobial resistance and evade immunity
Learn from the best in the industry. Our diverse team of highly experienced subject matter experts are passionate about sharing their knowledge with you.

If you have any questions about this course we have answered some of the most common ones below. If you still aren't finding what you're looking for you can contact our team here.
Yes, the Introduction to Pharmaceutical Microbiology course can be delivered in-house for your organisation. This can be arranged as an on-site course at your premises, or as a virtual tutor-led in-house course. Please see our In-house Training page for details.
Places will be available for you to book unless it states ‘Full’ next to your chosen Introduction to Pharmaceutical Microbiology course date. When this occurs, we operate a waiting list service.
Yes, we welcome bookings from self-sponsoring individuals. Once your booking has come through to us, we will ask you to complete a new customer form and provide a scanned copy of your photographic ID so that we can raise an account for you on our systems.
You will need to first register yourself on our booking system by selecting the Introduction to Pharmaceutical Microbiology course date that you wish to book your colleagues onto, then:
- Add the number of people you wish to book onto the course
- Register yourself as the booker and complete the fields accordingly
- Add the details of those you wish to book for
- Complete your order.
You will receive an automated email confirming your booking details for the Introduction to Pharmaceutical Microbiology course. 10 days before the start date, if the course is confirmed to run, you will receive another email including the final course details. If the course is to be held virtually, the online registration and joining instructions will also be included.
Usually, this 1-day Introduction to Pharmaceutical Microbiology course is delivered live by our tutor, virtually on the Adobe Connect training platform. If you are looking for in-person training only, please get in touch with the team to discuss your needs via trainingsales@rssl.com or +44 (0)118 918 4000.
When online, this course begins at 08:45am, although we request that you login at 08:30am for registration. For our in-person courses, refreshments are available from 08.30am, for a 08:45am start. The standard finish time is 17:00pm, though some courses will finish slightly earlier or later.
Please review your course confirmation email to double check the exact start time of your specific course. If you need an exact finishing time to allow for travel arrangements, please contact us via trainingsales@rssl.com or +44 (0)118 918 4000.
Your invoice will be sent approximately 30 days prior to the course start date. If you are a new customer to RSSL, shortly after we receive your booking, you will be asked to complete a New Customer Form so that an account can be created for you on our finance system.
Yes, companies wishing to book multiple employees on one of our standard training courses (excluding IRCA Lead Auditor courses) can benefit from our group booking discount. This discount is only applicable to bookings made for the same course on the same date. Please contact trainingsales@rssl.com with your requirements and we will be happy to provide more information on the best deal available for you.
Yes, we offer NHS Trusts a 20% discount on ALL our courses, including our Qualified Person training programme. When booking your course/s enter 'NHS' in the discount code field so that your discount can be applied on your invoice. Please note that the NHS discount code is only valid when the booker uses a NHS email address.
Yes, certificates of attendance are issued after we have received payment in full for the course. If you have not received your certificate, please contact your own finance department to confirm if they have sent payment to us. All certificates are issued electronically by email.
As RSSL run all of our virtual courses on Adobe Connect, we recommend that you download the latest version of the Adobe Connect Application at the time of your course - click here to visit the download webpage.
Please see our 'minimum requirements' document for further details on what you'll need to attend our virtual courses. You can test that the Adobe Connect application works for your organisation by completing the RSSL Adobe Connect Function Test.
Yes, we are more than happy to welcome delegates from all over the world. Our virtual tutor-led courses are particularly popular with international attendees.
All we request is that you have a good understanding of written and spoken English so that you can get the most out of the course. If you wish to attend an in-person course, please also check any visa requirements and await RSSL's full course confirmation before booking your travel to the UK.
Discover the feedback from our course alumni and learn why they chose RSSL to support their professional development.
We offer bespoke in-house training solutions to you and your organisation. Contact an expert today to talk about your team and your specific requirements.
As scientists ourselves, we’re passionate about collaboration and sharing our expertise to nurture the next generation. By helping them to develop and fulfil their potential, we can tackle 21st-century pharmaceutical scientific challenges more effectively.

More than 30 years of experience upskilling pharmaceutical professionals

Small-group training adjusted to individual learning styles and needs

50+ training courses accredited by recognised industry bodies

Combination of off-the-shelf and bespoke training packages

Courses and consulting led by experts in the entire pharmaceutical life cycle

Opportunity to share and learn as part of a diverse community